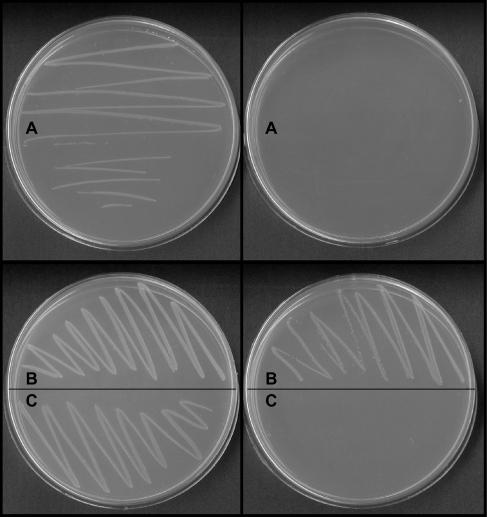
https://cdn.ncbi.nlm.nih.gov/pmc/blobs/fc61/2711008/4e6e6ef10d78/bi-2007-02453s_0001.jpg

来自结核分枝杆菌的Rv2131c是一种CysQ 3'-磷酸腺苷-5'-磷酸酶。
Rv2131c from Mycobacterium tuberculosis is a CysQ 3'-phosphoadenosine-5'-phosphatase.
作者信息
Hatzios Stavroula K, Iavarone Anthony T, Bertozzi Carolyn R
机构信息
Department of Chemistry, University of California, Berkeley, California 94720, USA.
出版信息
Biochemistry. 2008 May 27;47(21):5823-31. doi: 10.1021/bi702453s. Epub 2008 May 3.
Mycobacterium tuberculosis ( Mtb) produces a number of sulfur-containing metabolites that contribute to its pathogenesis and ability to survive in the host. These metabolites are products of the sulfate assimilation pathway. CysQ, a 3'-phosphoadenosine-5'-phosphatase, is considered an important regulator of this pathway in plants, yeast, and other bacteria. By controlling the pools of 3'-phosphoadenosine 5'-phosphate (PAP) and 3'-phosphoadenosine 5'-phosphosulfate (PAPS), CysQ has the potential to modulate flux in the biosynthesis of essential sulfur-containing metabolites. Bioinformatic analysis of the Mtb genome suggests the presence of a CysQ homologue encoded by the gene Rv2131c. However, a recent biochemical study assigned the protein's function as a class IV fructose-1,6-bisphosphatase. In the present study, we expressed Rv2131c heterologously and found that the protein dephosphorylates PAP in a magnesium-dependent manner, with optimal activity observed between pH 8.5 and pH 9.5 using 0.5 mM MgCl 2. A sensitive electrospray ionization mass spectrometry-based assay was used to extract the kinetic parameters for PAP, revealing a K m (8.1 +/- 3.1 microM) and k cat (5.4 +/- 1.1 s (-1)) comparable to those reported for other CysQ enzymes. The second-order rate constant for PAP was determined to be over 3 orders of magnitude greater than those determined for myo-inositol 1-phosphate (IMP) and fructose 1,6-bisphosphate (FBP), previously considered to be the primary substrates of this enzyme. Moreover, the ability of the Rv2131c-encoded enzyme to dephosphorylate PAP and PAPS in vivo was confirmed by functional complementation of an Escherichia coli Delta cysQ mutant. Taken together, these studies indicate that Rv2131c encodes a CysQ enzyme that may play a role in mycobacterial sulfur metabolism.
结核分枝杆菌(Mtb)产生多种含硫代谢物,这些代谢物有助于其发病机制及在宿主体内的生存能力。这些代谢物是硫酸盐同化途径的产物。CysQ是一种3'-磷酸腺苷-5'-磷酸酶,在植物、酵母和其他细菌中被认为是该途径的重要调节因子。通过控制3'-磷酸腺苷5'-磷酸(PAP)和3'-磷酸腺苷5'-磷酸硫酸酯(PAPS)的池,CysQ有可能调节必需含硫代谢物生物合成中的通量。对Mtb基因组的生物信息学分析表明存在由基因Rv2131c编码的CysQ同源物。然而,最近的一项生化研究将该蛋白质的功能指定为IV类果糖-1,6-二磷酸酶。在本研究中,我们异源表达了Rv2131c,发现该蛋白质以镁依赖性方式使PAP去磷酸化,在使用0.5 mM MgCl2时,在pH 8.5至pH 9.5之间观察到最佳活性。使用基于灵敏电喷雾电离质谱的测定法提取PAP的动力学参数,揭示出K m(8.1 +/- 3.1 microM)和k cat(5.4 +/- 1.1 s(-1))与其他CysQ酶报道的参数相当。确定PAP的二级速率常数比以前认为是该酶主要底物的肌醇1-磷酸(IMP)和果糖1,6-二磷酸(FBP)的二级速率常数大3个数量级以上。此外,通过大肠杆菌Delta cysQ突变体的功能互补证实了Rv2131c编码的酶在体内使PAP和PAPS去磷酸化的能力。综上所述,这些研究表明Rv2131c编码一种可能在分枝杆菌硫代谢中起作用的CysQ酶。